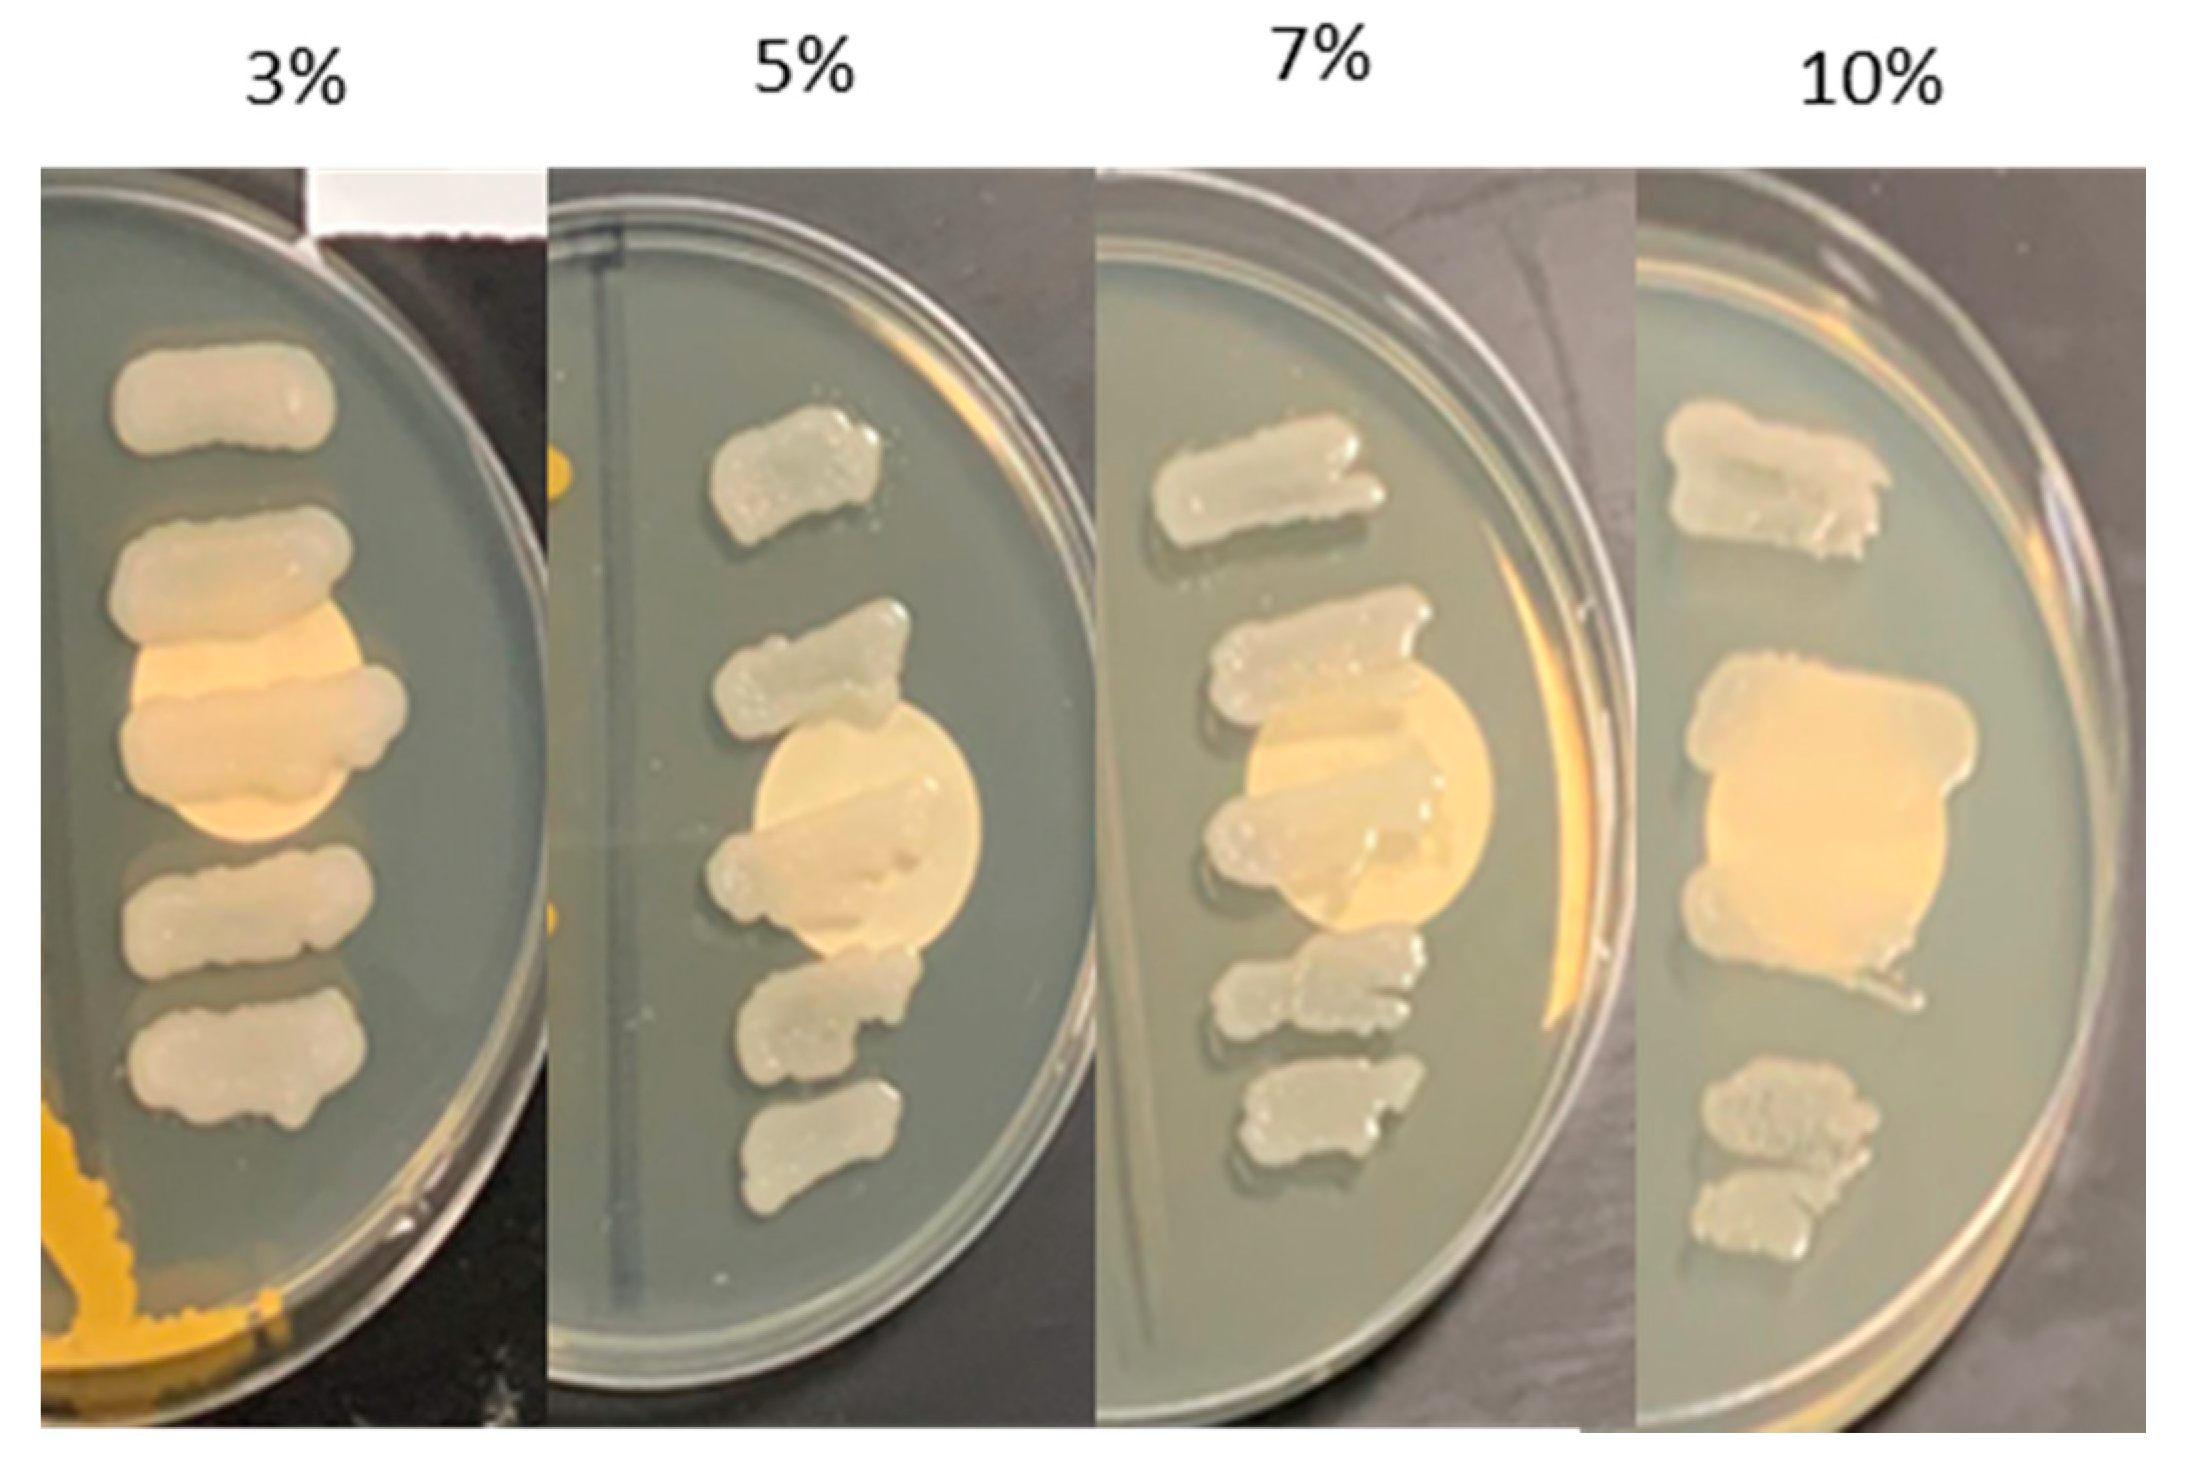
Agriculture 12 00873 g001 550

Plant Growth-Promoting Bacterium from Non-Agricultural Soil Improves Okra Plant Growth
Abstract
:1. Introduction
2. Materials and Methods
2.1. DPM17 Isolation and Parameters of the Soil Sample
2.2. Phenotypic Characterization
2.3. Genotypic Characterization Using 16S rRNA Gene Sequence
2.4. Plant Growth Promoting Features
2.5. Inoculation of Okra Plants with DPM17
2.6. Statistical Analysis
3. Results
3.1. Soil Parameters and Isolation and Characterization of the PGPB
3.2. Effect of DPM17 on Okra Growth
4. Discussion
5. Conclusions
Author Contributions
Funding
Institutional Review Board Statement
Informed Consent Statement
Data Availability Statement
Acknowledgments
Conflicts of Interest
References
- Dincă, L.C.; Grenni, P.; Onet, C.; Onet, A. Fertilization and soil microbial community: A review. Appl. Sci. 2022, 12, 1198. [Google Scholar] [CrossRef]
- Eze, M.O.; Thiel, V.; Hose, G.C.; George, S.C.; Daniel, R. Enhancing rhizoremediation of petroleum hydrocarbons through bioaugmentation with a plant growth-promoting bacterial consortium. Chemosphere 2022, 289, 133143. [Google Scholar] [CrossRef]
- Al-Tarawneh, A.; Khleifat, K.M.; Tarawneh, I.N.; Shiyyab, K.; El-Hasan, T.; Sprocati, A.R.; Alqaraleh, M. Phenol biodegradation by plant growth promoting bacterium, S. odorifera: Kinetic modeling and process optimization. Arch. Microbiol. 2022, 204, 104. [Google Scholar] [CrossRef] [PubMed]
- Wang, X.; Cai, D.; Ji, M.; Chen, Z.; Yao, L.; Han, H. Isolation of heavy metal-immobilizing and plant growth-promoting bacteria and their potential in reducing Cd and Pb uptake in water spinach. Sci. Total Environ. 2022, 819, 153242. [Google Scholar] [CrossRef]
- Benchasri, S. Okra (Abelmoschus esculentus (L.) Moench) as a valuable vegetable of the world. Ratar. Povrt. 2012, 49, 105–112. [Google Scholar]
- El Amin, O.A.H.; El-kersh, M.A.M.; Azooz, M.M. Application of hemin-induced growth and biochemical modifications in Hassawi okra (‘Abelmoschus esculentus’ L.) grown in seawater salinity. Aust. J. Crop. Sci. 2020, 14, 705. [Google Scholar] [CrossRef]
- Houida, S.; Yakkou, L.; Kaya, L.O.; Bilen, S.; Fadil, M.; Raouane, M.; El Harti, A.; Amghar, S. Biopriming of maize seeds with plant growth-promoting bacteria isolated from the earthworm Aporrectodea molleri: Effect on seed germination and seedling growth. Lett. Appl. Microbiol. 2022, in press. [CrossRef] [PubMed]
- Khalifa, A.Y.; Almalki, M.A. Isolation and characterization of an endophytic bacterium, Bacillus megaterium BMN1, associated with root-nodules of Medicago sativa L. growing in Al-Ahsaa region Saudi Arabia. Annal. Microbiol. 2015, 65, 1017–1026. [Google Scholar] [CrossRef]
- Khalifa, A.Y.; Alsyeeh, A.-M.; Almalki, M.A.; Saleh, F.A. Characterization of the plant growth promoting bacterium, Enterobacter cloacae MSR1, isolated from roots of non-nodulating Medicago sativa. Saudi. J. Biol. Sci. 2016, 23, 79–86. [Google Scholar] [CrossRef] [PubMed]
- Khalifa, A.Y.; Almalki, M. Polyphasic characterization of Delftia acidovorans ESM-1, a facultative methylotrophic bacterium isolated from rhizosphere of Eruca sativa. Saudi. J. Biol. Sci. 2019, 26, 1262–1267. [Google Scholar] [CrossRef] [PubMed]
- Khalifa, A.Y.; Metwally, A.; Ammar, R.B.; Farghaly, F.A. ACC deaminase-containing rhizobacteria from rhizosphere of Zygophyllum coccineum alleviate salt stress impact on wheat (Triticum aestivum L.). Sci. J. King Faisal. Univ. 2020, 21, 89–101. [Google Scholar] [CrossRef]
- Aldayel, M.F.; Khalifa, A. Isolation and characterization of bacteria from tomato and assessment of its plant growth promoting traits in three economically important crops in Al-Ahsa region, Saudi Arabia. J. Environ. Biol. 2021, 42, 973–981. [Google Scholar] [CrossRef]
- Corwin, D.L.; Yemoto, K. Salinity: Electrical conductivity and total dissolved solids. Soil. Sci. Soc. J. Am. 2017, 84, 1442–1461. [Google Scholar] [CrossRef]
- Sharma, S.; Kulkarni, J.; Jha, B. Halotolerant rhizobacteria promote growth and enhance salinity tolerance in peanut. Front. Microbiol. 2016, 7, 1600–1611. [Google Scholar] [CrossRef] [PubMed] [Green Version]
- Rasool, A.; Mir, M.I.; Zulfajri, M.; Hanafiah, M.M.; Unnisa, S.A.; Mahboob, M. Plant growth promoting and antifungal asset of indigenous rhizobacteria secluded from saffron (Crocus sativus L.) rhizosphere. Microb. Pathog. 2021, 150, 104734. [Google Scholar] [CrossRef]
- Rørth, M.; Jensen, P. Determination of catalase activity by means of the Clark oxygen electrode. Biochim. Biophys. Acta 1967, 139, 171–173. [Google Scholar] [CrossRef]
- Lee, J.-G.; Cheong, K.H.; Huh, N.; Kim, S.; Choi, J.-W.; Ko, C. Microchip-based one step DNA extraction and real-time PCR in one chamber for rapid pathogen identification. Lab Chip 2006, 6, 886–895. [Google Scholar] [CrossRef] [PubMed]
- Kumar, S.; Stecher, G.; Tamura, K. MEGA7: Molecular evolutionary genetics analysis version 7.0 for bigger datasets. Mol. Biol. Evol. 2016, 33, 1870–1874. [Google Scholar] [CrossRef] [PubMed] [Green Version]
- Saitou, N.; Nei, M. The neighbor-joining method: A new method for reconstructing phylogenetic trees. Mol. Biol. Evol. 1987, 4, 406–425. [Google Scholar] [PubMed]
- Tamura, K.; Nei, M.; Kumar, S. Prospects for inferring very large phylogenies by using the neighbor-joining method. Proc. Natl. Acad. Sci. USA 2004, 101, 11030–11035. [Google Scholar] [CrossRef] [PubMed] [Green Version]
- Kayasth, M.; Gera, R.; Dudeja, S.S.; Sharma, P.K.; Kumar, V. Studies on salinization in Haryana soils on free-living nitrogen-fixing bacterial populations and their activity. J. Basic Microbiol. 2014, 54, 170–179. [Google Scholar] [CrossRef] [PubMed]
- Pikovskaya, R. Mobilization of phosphorus in soil in connection with vital activity of some microbial species. Mikrobiologiya 1948, 17, 362–370. [Google Scholar]
- Gordon, S.A.; Weber, R.P. Colorimetric estimation of indoleacetic acid. Plant Physiol. 1951, 26, 192. [Google Scholar] [CrossRef] [PubMed] [Green Version]
- Vyas, P.; Kumar, D.; Dubey, A.; Kumar, A. Screening and characterization of Achromobacter xylosoxidans isolated from rhizosphere of Jatropha curcas L.(energy crop) for plant-growth-promoting traits. J. Adv. Res. Biotechnol. 2018, 3, 1–8. [Google Scholar]
- Restu, M.; Bachtiar, B.; Larekeng, S. Gibberellin and IAA Production by Rhizobacteria from Various Private Forest. In IOP Conference Series: Earth and Environmental Science; IOP Publishing: Bristol, UK, 2019; p. 012018. [Google Scholar]
- Sulieman, M.; Sallam, A.E.A. Improved method to determine particle size distribution for some gypsiferous soils. A case study from Al-Ahsa Governorate, Saudi Arabia. Eurasian J. Soil. Sci. 2016, 5, 322–331. [Google Scholar] [CrossRef]
- Mohammed, M.; El Mahmoudi, A.; Almolhem, Y. Applications of electromagnetic induction and electrical resistivity tomography for digital monitoring and assessment of the soil: A case study of Al-Ahsa oasis, Saudi Arabia. Appl. Sci. 2022, 12, 206. [Google Scholar] [CrossRef]
- Nawar, S.; Buddenbaum, H.; Hill, J.; Kozak, J. Modeling and mapping of soil salinity with reflectance spectroscopy and landsat data using two quantitative methods (PLSR and MARS). Remote Sens. 2014, 6, 10813–10834. [Google Scholar] [CrossRef] [Green Version]
- Mustafa, G.; Akhtar, M.S.; Abdullah, R. Global concern for salinity on various agro-ecosystems. In Salt Stress, Microbes, and Plant Interactions: Causes and Solution; Akhtar, M., Ed.; Springer: Singapore, 2019. [Google Scholar]
- Kumar, A.; Singh, S.; Mukherjee, A.; Rastogi, R.P.; Verma, J.P. Salt-tolerant plant growth-promoting Bacillus pumilus strain JPVS11 to enhance plant growth attributes of rice and improve soil health under salinity stress. Microbiol. Res. 2021, 242, 126616. [Google Scholar] [CrossRef]
- Liu, Y.; Lai, Q.; Shao, Z. Identification of “Bacillus cellulasensis” strain NIO-1130 T as a member of Bacillus altitudinis and emendation of the latter. Arch. Microbiol. 2016, 198, 835–838. [Google Scholar] [CrossRef]
- Sohaib, M.; Zahir, Z.A.; Khan, M.Y.; Ans, M.; Asghar, H.N.; Yasin, S.; Al-Barakah, F.N. Comparative evaluation of different carrier-based multi-strain bacterial formulations to mitigate the salt stress in wheat. Saudi. J. Biol. Sci. 2020, 27, 777–787. [Google Scholar] [CrossRef]
- Fan, D.; Smith, D.L. Characterization of selected plant growth-promoting rhizobacteria and their non-host growth promotion effects. Microbiol. Spectr. 2021, 9, e00279–e00321. [Google Scholar] [CrossRef] [PubMed]
- AlAli, H.A.; Khalifa, A.; Almalki, M. Plant growth-promoting rhizobacteria from Ocimum basilicum improve growth of Phaseolus vulgaris and Abelmoschus esculentus. S. Afr. J. Bot. 2021, 139, 200–209. [Google Scholar] [CrossRef]
- Chinachanta, K.; Shutsrirung, A.; Herrmann, L.; Lesueur, D. Isolation and characterization of KDML105 aromatic rice rhizobacteria producing indole-3-acetic acid: Impact of organic and conventional paddy rice practices. Lett. Appl. Microbiol. 2022, 74, 354–366. [Google Scholar] [CrossRef]
- Lam, V.P.; Lee, M.H.; Park, J.S. Optimization of indole-3-acetic acid concentration in a nutrient solution for increasing bioactive compound accumulation and production of Agastache rugosa in a plant factory. Agriculture 2020, 10, 343. [Google Scholar] [CrossRef]
- Acuña, J.J.; Jorquera, M.A.; Martínez, O.A.; Menezes-Blackburn, D.; Fernández, M.T.; Marschner, P.; Greiner, R.; Mora, M. Indole acetic acid and phytase activity produced by rhizosphere bacilli as affected by pH and metals. J. Soil. Sci. Plant Nutr. 2011, 11, 1–12. [Google Scholar]
- Castro-Camba, R.; Sánchez, C.; Vidal, N.; Vielba, J.M. Interactions of gibberellins with phytohormones and their role in stress responses. Horticulturae 2022, 8, 241. [Google Scholar] [CrossRef]
- Shahzad, R.; Waqas, M.; Khan, A.L.; Asaf, S.; Khan, M.A.; Kang, S.M.; Yun, B.W.; Lee, I.J. Seed-borne endophytic Bacillus amyloliquefaciens RWL-1 produces gibberellins and regulates endogenous phytohormones of Oryza sativa. Plant Physiol. Biochem. 2016, 106, 236–243. [Google Scholar] [CrossRef]
- Kang, S.M.; Hamayun, M.; Khan, M.A.; Iqbal, A.; Lee, I.J. Bacillus subtilis JW1 enhances plant growth and nutrient uptake of Chinese cabbage through gibberellins secretion. J. Appl. Bot. Food Qual. 2019, 92, 172–178. [Google Scholar]
- Essalimi, B.; Esserti, S.; Rifai, L.A.; Koussa, T.; Makroum, K.; Belfaiza, M.; Rifai, S.; Stéphane, J.V.; Faize, L.; Alburquerque, N.; et al. Enhancement of plant growth, acclimatization, salt stress tolerance and verticillium wilt disease resistance using plant growth-promoting rhizobacteria (PGPR) associated with plum trees (Prunus domestica). Sci. Hortic. 2022, 291, 110621. [Google Scholar] [CrossRef]
- Lekota, K.E.; Bezuidt, O.K.I.; Mafofo, J.; Rees, J.; Muchadeyi, F.C.; Madoroba, E.; Van Heerden, H. Whole genome sequencing and identification of Bacillus endophyticus and B. anthracis isolated from anthrax outbreaks in South Africa. BMC Microbiol. 2018, 18, 67. [Google Scholar] [CrossRef]
- He, Y.; Pantigoso, H.A.; Wu, Z.; Vivanco, J.M. Co-inoculation of Bacillus sp. and Pseudomonas putida at different development stages acts as a biostimulant to promote growth, yield and nutrient uptake of tomato. J. Appl. Microbiol. 2019, 127, 196–207. [Google Scholar] [CrossRef] [PubMed]

| Morphological Features | DPM17 |
|---|---|
| Colony shape | Circular |
| Color | White |
| Colony diameter | 1–3 mm |
| Colony elevation | Raised |
| Colony margin | Undulate |
| Gram reaction | gram-positive |
| ONPG * (Beta-galactosidase) | + |
| Arginine (Arginine dihydrolase) | + |
| Lysine (Lysine decarboxylase) | − |
| Ornithine (Ornithine decarboxylase) | − |
| Citrate (Citrate utilization) | − |
| Na thiosulfate (H2S production) | − |
| Urea (Urea hydrolysis) | − |
| Tryptophan (Deaminase) | + |
| Indole (Indole production) | + |
| Na pyruvate (Acetoin production) | + |
| Charcoal gelatin (Gelatinase) | + |
| Glucose (Fermentation/oxidation) | + |
| Mannitol (Fermentation/oxidation) | + |
| Inositol (Fermentation/oxidation) | + |
| Sorbitol (Fermentation/oxidation) | + |
| Rhamnose (Fermentation/oxidation) | − |
| Sucrose (Fermentation/oxidation) | + |
| Melibiose (Fermentation/oxidation) | + |
| Amygdalin (Fermentation/oxidation) | + |
| Arabinose (Fermentation/oxidation) | + |
| Catalase (Oxidation/reduction) | + |
| Amylase (Starch hydrolysis) | + |
| Growth under salt stress (0–10% NaCl) | + |
| Nitrogen fixation | − |
| Phosphate solubilization | + |
| Indole acetic acid (IAA) production | 4.51–5.04 μg mL−1 |
| Ammonia production | 0.06 µg mL−1 |
| Gibberellin (GA3) production | 1.33 µg mL−1 |
| Catalase test | + |
| Closest strain | Bacillus sp. |
| Identity (%) | 96.51 |
| Accession number | MT949889 |
| Growth Parameter | Control | DMP17-Treated |
|---|---|---|
| Root length (cm) | 7.03 ± 0.33 | 9.41 * ± 0.34 |
| Stem length (cm) | 17.86 ± 0.27 | 19.1 * ± 1.16 |
| Lateral root count plant−1 | 3.2 ± 0.44 | 7.2 * ± 0.83 |
| Dry weight root plant −1 (mg) | 6.34 ± 0.23 | 13.3 * ± 0.25 |
| Dry weight shoot plant−1 (mg) | 26.1 ± 0.41 | 28.3 * ± 0.47 |
Publisher’s Note: MDPI stays neutral with regard to jurisdictional claims in published maps and institutional affiliations. |
© 2022 by the authors. Licensee MDPI, Basel, Switzerland. This article is an open access article distributed under the terms and conditions of the Creative Commons Attribution (CC BY) license (https://creativecommons.org/licenses/by/4.0/).
Share and Cite
AlAli, H.A.; Khalifa, A.; Almalki, M. Plant Growth-Promoting Bacterium from Non-Agricultural Soil Improves Okra Plant Growth. Agriculture 2022, 12, 873. https://doi.org/10.3390/agriculture12060873
AlAli HA, Khalifa A, Almalki M. Plant Growth-Promoting Bacterium from Non-Agricultural Soil Improves Okra Plant Growth. Agriculture. 2022; 12(6):873. https://doi.org/10.3390/agriculture12060873
Chicago/Turabian StyleAlAli, Heba Adel, Ashraf Khalifa, and Mohammed Almalki. 2022. "Plant Growth-Promoting Bacterium from Non-Agricultural Soil Improves Okra Plant Growth" Agriculture 12, no. 6: 873. https://doi.org/10.3390/agriculture12060873
APA StyleAlAli, H. A., Khalifa, A., & Almalki, M. (2022). Plant Growth-Promoting Bacterium from Non-Agricultural Soil Improves Okra Plant Growth. Agriculture, 12(6), 873. https://doi.org/10.3390/agriculture12060873

